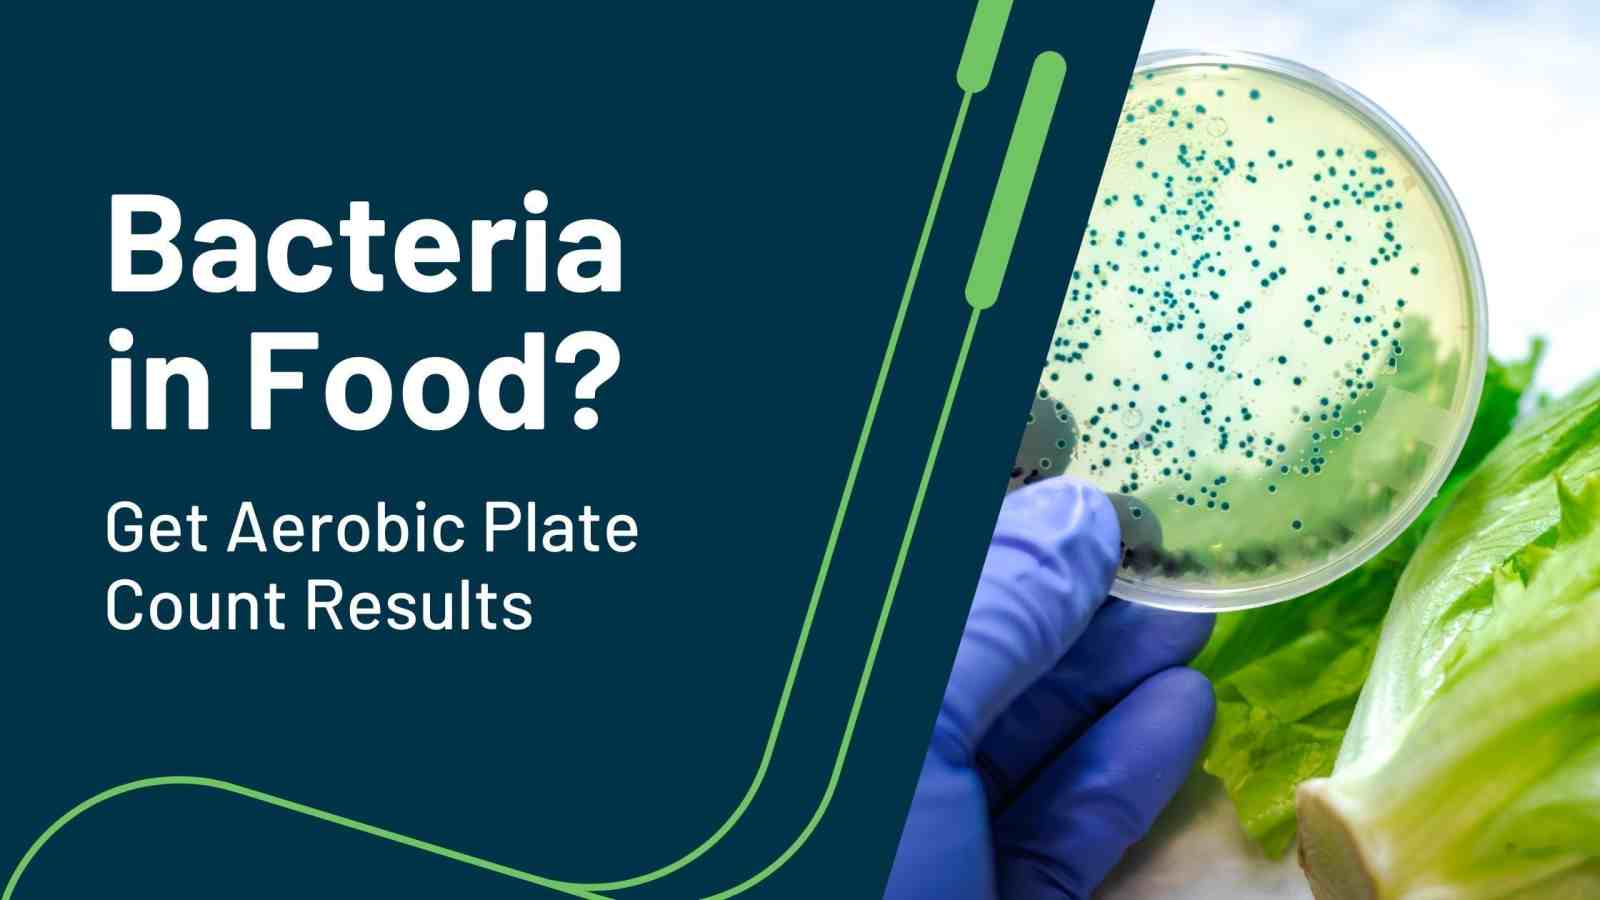
Example

Lab Testing Supplements for Heavy Metals and PFAS: SimpleLab Guide

With the growth of the multivitamin and dietary supplement market comes an increasing need for quality assurance. Supplement testing at a certified laboratory helps verify purity, potency, and safety — whether you’re a consumer checking what’s in your capsules or a manufacturer validating product integrity.
SimpleLab offers a comprehensive range of mail-to-lab supplement testing kits designed for easy at-home sampling and professional analysis. Below, we’ll explore each kit, and what contaminants, adulterants, and unwanted additives can be tested.
Table of Contents:
- Choose the Right Supplement Test Kit
- How Does It Work?
- When to Test?
- Relevant Industries & Kits
- Questions?
Choosing the Right Supplement Testing Kit
Third party supplement testing can ensure products are free from harmful substances and that ingredient claims are accurate. Each SimpleLab supplement test kit targets a specific class of contaminants or additives commonly found in raw materials, powders, and finished products.
-
Heavy Metals Dietary Supplement Test: Detects key toxic metals (like the “Big 4” of lead, arsenic, cadmium, and mercury) at standard detection limits suitable for most finished supplements. Studies of dietary supplements (including plant-based powders, protein supplements, multivitamin/mineral products) have found detectable levels of heavy metals.[1]
-
Low-Level Heavy Metals Dietary Supplement Test: Measures trace metals at lower detection levels, ideal for high-purity formulations, infant products, or research-grade verification.
-
Artificial Sweeteners Dietary Supplement Test: Screens for common synthetic sweeteners and sugar alcohols (e.g., aspartame, sucralose, saccharin) that may appear in pre-workouts, protein powders, or energy blends. Sweeteners are common additives in flavor-enhanced supplements.
-
Metals Dietary Supplement Test: Measures a broad range of elemental metals, including both essential minerals like iron and zinc to potential contaminants like chromium and antimony.
-
Minerals Supplement Test: Quantifies beneficial nutrients such as magnesium, zinc, and calcium to confirm nutritional label accuracy.
-
Microplastics Supplement Test: Detects microplastic particles that may contaminate raw ingredients during manufacturing or packaging. Recent studies have shown evidence of microplastics in food and supplements.[2-4]
-
PFAS Dietary Supplement Test: Analyzes for “forever chemicals” (per- and polyfluoroalkyl substances) that can migrate from packaging or manufacturing equipment into supplements. Identifies and quantifies PFAS at trace levels.
All kits are processed by certified laboratories and analyzed using validated methods. Analysis methods include:
- ICP-MS (Inductively Coupled Plasma Mass Spectrometry) for metals and minerals
- LC-MS/MS (Liquid Chromatography–Tandem Mass Spectrometry) for PFAS and sweeteners
- Microanalytical imaging for microplastics.
Lab testing of supplements results in clear, defensible data that helps protect consumer safety and brand reputation.
Each kit includes:
- Sampling materials appropriate for the matrix
- Prepaid shipping
- Certified laboratory analysis
- Chain of custody documentation
- Easy-to-follow instructions
- Digital report-back viewable through a professional dashboard
How Do the Tests Work?
SimpleLab supplement kits are mail-to-lab test kits — no on-site technician or complex equipment required. All the work is done at the laboratory. Each kit includes all materials needed for sampling, prepaid shipping, and step-by-step instructions.
-
Collect a Small Sample
Place the appropriately measured portion of powder, tablet, or capsule in the provided sample container. The instructions specify how much material to include.
-
Ship to the Certified Laboratory
Use the included prepaid mailer to send your sample directly to the testing lab.
-
Laboratory Analysis
Depending on the kit type:
- Metals and Minerals Tests use ICP-MS for precise elemental quantification.
- PFAS and Artificial Sweeteners Tests use LC-MS/MS to identify trace organic compounds.
-
Microplastics Tests use filtration and microscopy to detect and classify plastic particles.
-
Digital Report Delivery
Within days, you’ll receive a secure, easy-to-read digital report detailing concentrations and any exceedances against reference standards (e.g., USP, EPA, or EFSA guidelines). SimpleLab’s Commercial Accounts include business-friendly additions like pro pricing and secured sharing options.
By outsourcing analysis to a certified laboratory, you eliminate the guesswork and potential inaccuracies of handheld or DIY test kits. Third party supplement testing also ensures integrity through rigorous certification and quality control processes. With SimpleLab, you don’t need to search for a supplement testing lab, we handle that part for you.
When To Test Multivitamins & Dietary Supplements
Lab testing of supplements is recommended whenever product quality or purity is uncertain. This is especially important in a market where regulation varies and supply chains are global.
Common testing scenarios include:
- Formulators and Brands: Quality control during production or before product launch.
- Contract Manufacturers: Verification of incoming raw materials or finished batches.
- Retailers and Distributors: Independent validation of label claims or compliance.
- Researchers: Ingredient verification for studies requiring chemical purity.
- Consumers: Personal assurance that supplements are free from contaminants.
Testing is especially critical for:
- Imported or bulk ingredients without full documentation
- Private-label or white-label products
- High-performance supplements for athletes
- Supplements targeted at vulnerable populations (infants, pregnant individuals, elderly)
SimpleLab’s flexible testing suite ensures you can choose the right kit based on your need — from broad metal screening to advanced PFAS detection:
Heavy Metals Dietary Supplement Test
$207.00
Low Level Heavy Metals Dietary Supplement Test
$210.00
Artificial Sweeteners Dietary Supplement Test
$282.00
Metals Dietary Supplement Test
$438.00
Minerals Dietary Supplement Test
$453.00
Microplastics Dietary Supplement Test
$909.00
PFAS Dietary Supplement Test
$1426.00
Questions? Contact Us
The supplement industry runs on trust — and trust begins with data. SimpleLab’s mail-to-lab supplement testing kits offer reliable, accredited analysis for every stage of production and consumption.
If you have any questions about testing with SimpleLab, reach out to our customer support team any time.
The SimpleLab Standard
-
Proven Reliability: SimpleLab partners with North America's leading analytical institutions—including Eurofins, Pace Analytical, SGS, and Microbac—each with their own rigorous quality control protocols to ensure top-tier accuracy. Our certified labs are located across all 50 states, making logistics a breeze.
-
Simplified Sampling: Every kit includes professional-grade materials, clear instructions, automated chain of custody, and free return shipping— making accurate testing effortless.
-
Seamless Experience: We combine human support with automated logistics to help make complex lab analyses accessible to all. From our user interface to our lab reports, we ensure a time-saving, frustration-free process.
Sam brings expertise in water chemistry and environmental engineering to support scientific standards at SimpleLab. She earned Bachelor’s and Master’s degrees in Environmental Engineering and has experience in environmental analytical chemistry research.
About SimpleLab
SimpleLab combines world-class laboratory science with customer service to ensure testing your environment is simple, fast and factual. Everything we do is driven by data and supported by a team of experts ready to answer your questions.